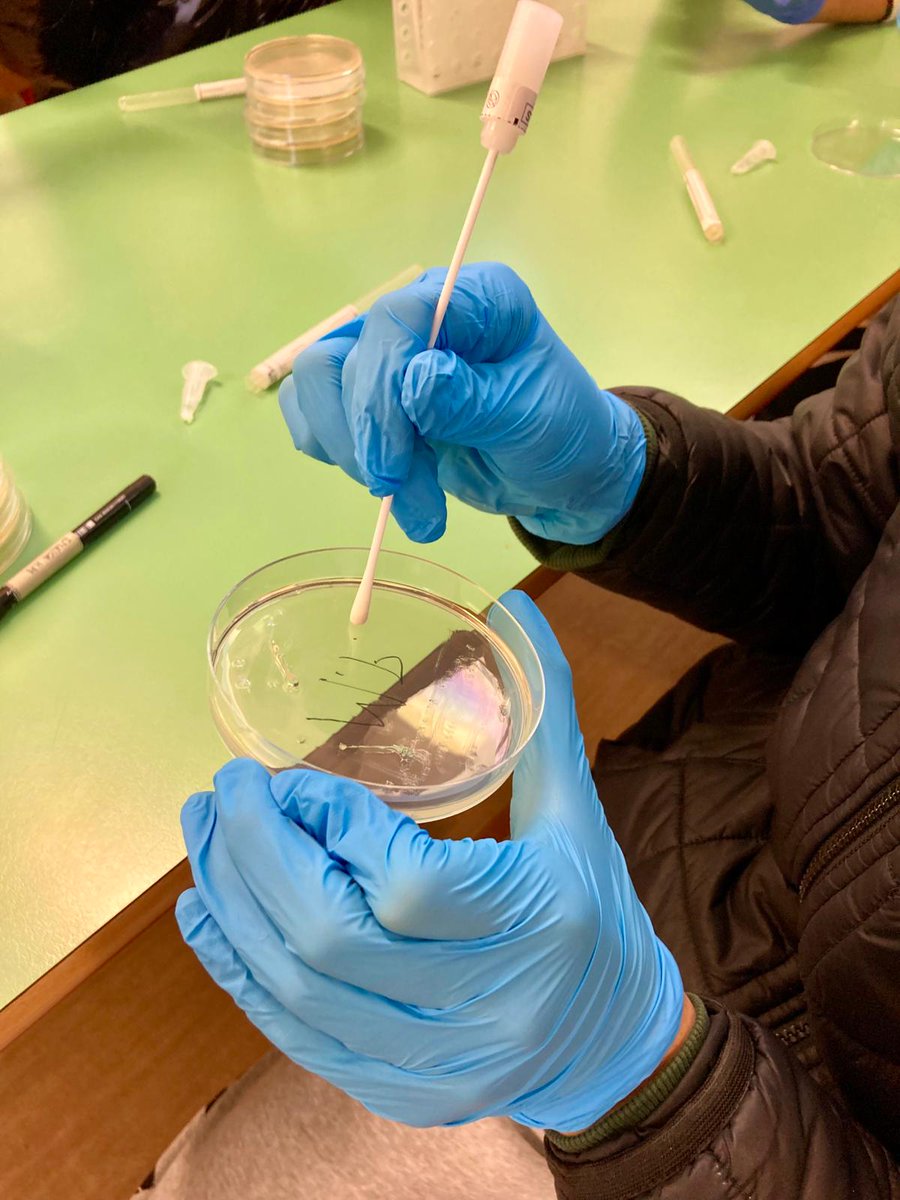
Dipartimento di Medicina Molecolare DMM - Unipd tweet media

Dipartimento di Medicina Molecolare DMM - Unipd
182 posts


@DMM_Unipd
Il canale ufficiale del Dipartimento di Medicina Molecolare dell'Università degli Studi di Padova. Consulta la policy di Ateneo: https://t.co/fgTr7iot0F










New human model for muscle-induced cancer cachexia We developed neuromuscular organoid platform to study tumor-induced muscle wasting Grateful to all co-authors and supporters @AIRC_it @DMM_Unipd @cittadlsperanza Read the paper 👉 tinyurl.com/CACHEXIANMO Graphics by @maxxxx9_

Exciting work from our lab! @manuconlaccento and @FrassonIlaria showed the first evidence of #iMotifs in human Alphaherpesvirus promoters, where they form alongside #G4s. Potential new target for antiviral therapies? bit.ly/3WC08sq @SaraNRichter_ @DMM_Unipd #nonBDNA











